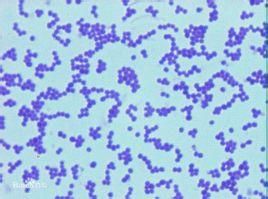
化膿性球菌 化膿性球菌

簡介
化膿性球菌化膿球菌是一類能夠感染人體並引起化膿性炎症的細菌。化膿性細菌對人體有致病性,常引起皮膚、皮下軟組織、深部組織的化膿性感染乃至內臟器官的膿腫,也能引起膿毒血症。化膿性細菌種類較多,有球菌也有桿菌;有革蘭陽性細菌也有革蘭陰性細菌;有需氧菌、兼性厭氧菌也有厭氧菌。一般把對人類有致病性的化膿性細菌分為兩大類:化膿性球菌和化膿性桿菌。化膿性細菌引起的感染在臨床上有重要意義,常引起創傷感染和醫院內感染中的化膿性感染。
知識
球菌是細菌中的一大類。對人類有致病性的病原性球菌(Pathogeniccoccus)主要引起化膿性炎症,所以稱為化膿性球菌(Pyogeniccoccus),其中革蘭氏陽性菌主要包括葡萄球菌、鏈球菌、肺炎球菌;革蘭氏陰性菌包括腦膜炎球菌和淋球菌等。
感染年齡
化膿菌傳染性皮膚病是接觸傳染病,蔓延迅速,多見於2—8歲的小兒,常流行於幼稚園及國小。我國每年自4月開始出現,至8—9月為發病的最盛時期。一般無全身症狀,經過適當治療即可痊癒,但重症者往往並發淋巴管炎、淋巴結炎,甚至引起急性腎小球腎炎。膿皰瘡俗稱黃水瘡,是一種最常見的化膿球菌傳染性皮膚病,系接觸傳染。